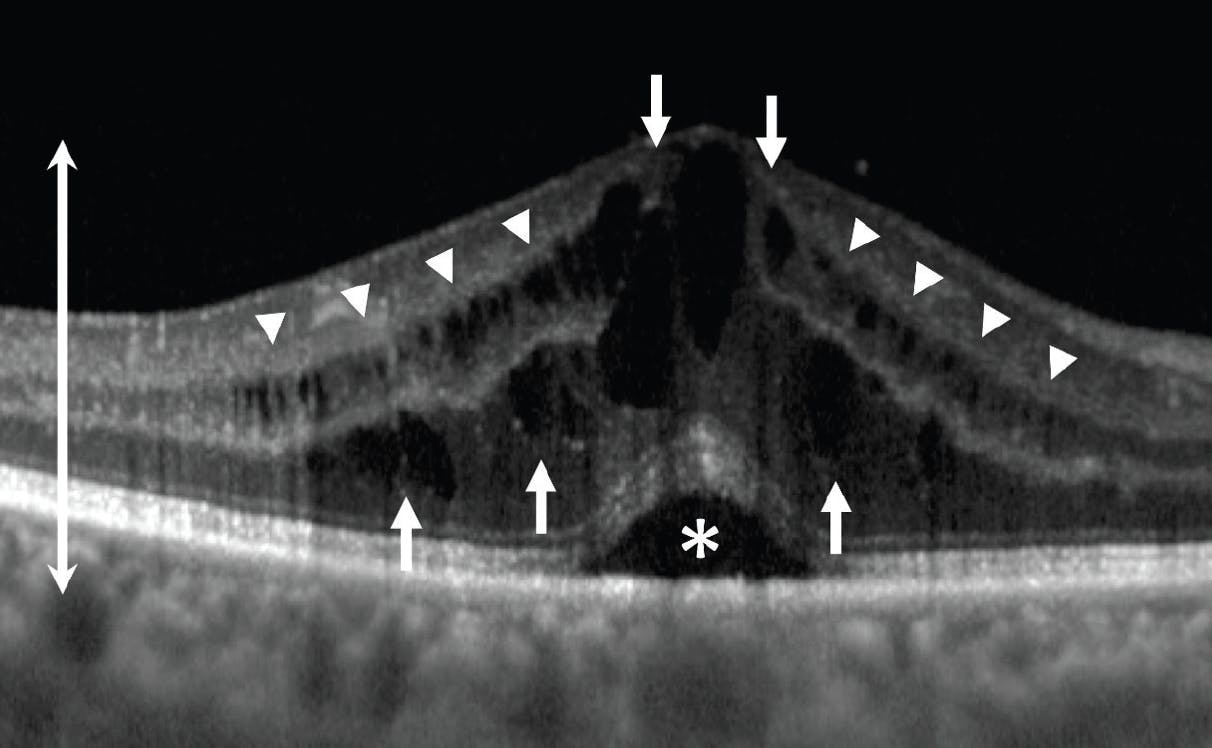
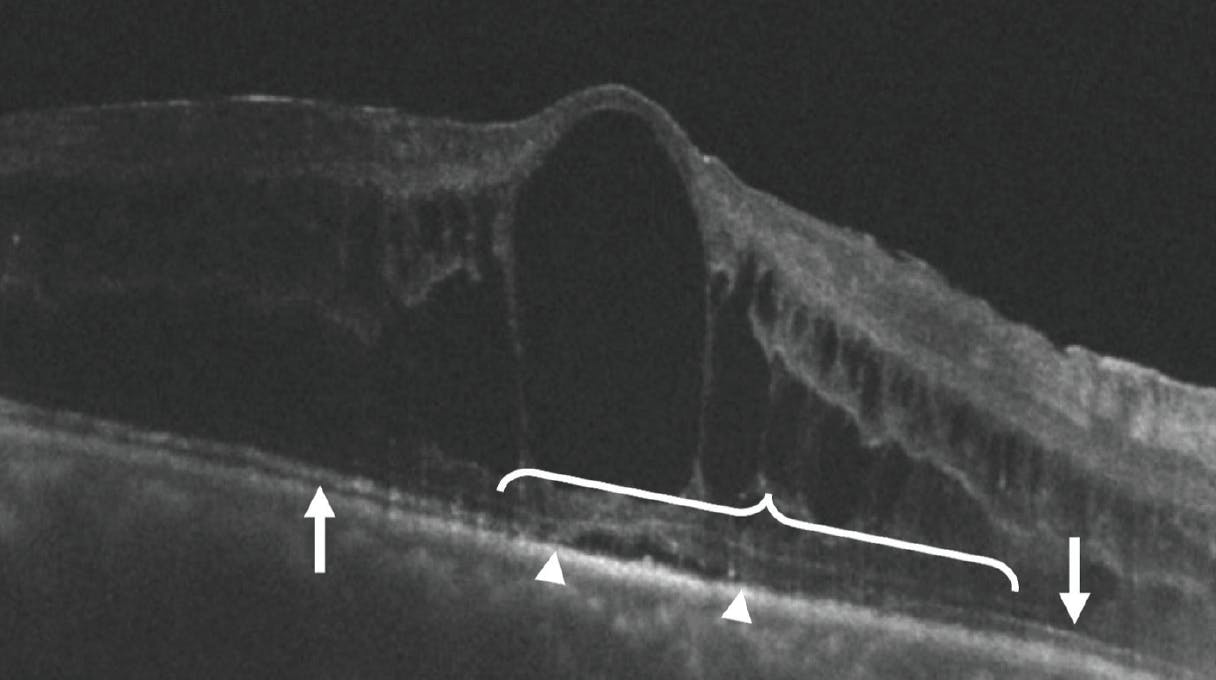

AT A GLANCE
- Several OCT biomarkers have been proposed as measures of disease severity and visual prognosis in uveitic macular edema.
- Tracking central subfield thickness at baseline and across treatment sessions may hold some value in clinical prognostication and patient counseling.
- Recent research suggests that foveal disorganization of retinal inner layers could be a valuable biomarker for BCVA in uveitic macular edema in addition to ellipsoid zone integrity and central subfield thickness.
Macular edema (ME) is the most common cause of vision loss in intraocular inflammatory disease and is a common feature of active uveitis.1,2 However, the diagnosis and management of uveitic ME (UME) can be challenging, owing in part to its often subtle examination findings and variable effects on visual acuity. Inconsistent correlations between UME severity, response to treatment, and visual prognosis can complicate the development of individualized treatment plans and make it difficult to provide patients with accurate prognostic counseling.
OCT has revolutionized the field of ophthalmology by providing a simple, noninvasive modality for reliably studying the microscopic cross-sectional structure of the retina in vivo. Several OCT biomarkers have been proposed as measures of disease severity and visual prognosis in UME, such as microscopic patterns of ME, central subfield thickness (CST), ellipsoid zone (EZ) integrity, and disorganization of retinal inner layers (DRIL).
Research continues to enhance our understanding of the correlations between these OCT biomarkers, baseline BCVA, and visual prognosis.3-5 Here, we provide a brief overview of the use of these various biomarkers as indicators of visual function and long-term prognosis in UME.
PATTERNS
Three major patterns of ME have been described based on their OCT appearance (Figure 1).6,7 The most common pattern, cystoid ME (CME), is characterized by clearly defined, large, low-reflective intraretinal spaces.7 Diffuse ME is characterized by generalized increased retinal thickness with small, sponge-like, low-reflective spaces. Serous retinal detachment is a clean separation of the neurosensory retina from the retinal pigment epithelium.7 Correlations between each of these OCT patterns and baseline BCVA, response to treatment, and long-term visual prognosis in UME have been widely studied.8
Figure 1. This OCT image demonstrates all three major patterns of ME in one unlucky patient. CME (arrows) appears as large, clearly defined, cystoid spaces. Diffuse ME (arrow heads) appears as small, sponge-like, low-reflective areas. Serous retinal detachment (asterisk) appears as a clean separation of the neurosensory retina from the retinal pigment epithelium. ME is also associated with increased central retinal thickness (double-headed arrow).
CENTRAL SUBFIELD THICKNESS
One of the simplest objective OCT measures of the degree of ME is retinal thickness.9 The most useful measure of retinal thickness as a biomarker of visual prognosis is CST, calculated by OCT software as the average thickness (in microns) across a 1-mm diameter circular area centered around the fovea (from the internal limiting membrane to the inner third of the retinal pigment epithelium on Cirrus OCT (Carl Zeiss Meditec), to Bruchs membrane on the Spectralis OCT (Heidelberg Engineering), or to the EZ on the Stratus OCT (Carl Zeiss Meditec). CST serves as a reliable, objective measure of the severity of vision-threatening ME and can be tracked over time.10
Increased CST has been shown to correlate negatively with baseline BCVA and visual prognosis in ME.11 However, early studies of CST in UME demonstrated only a weak correlation between macular thickness and visual acuity.6,12,13 More recently, data from 128 eyes enrolled in the Multicenter Uveitis Steroid Treatment (MUST) trial suggested a moderately negative correlation between CST and BCVA at baseline, as well as between change in CST and change in BCVA at 6 months.14
MUST trial data also demonstrated a 6.5-letter increase in BCVA on average for every 100-µm reduction in CST following therapy,14 whereas other studies showed that eyes with UME that achieved at least a 20% decrease in CST tended to demonstrate an increase in BCVA of at least 10 to 15 letters.14,15 Notably, some research has suggested that CST may be more strongly correlated with visual acuity in CME compared with other patterns of UME.13
A recent pooled analysis of 198 UME patients enrolled in the PEACHTREE and AZALEA trials examined the use of suprachoroidal injection of a triamcinolone acetonide corticosteroid formulation (CLS-TA, Clearside Biomedical) in ME and found only a moderately negative correlation between CST and BCVA at baseline, with CST accounting for 14.6% of the variation in baseline BCVA.11 There was also a moderately negative correlation in the change from baseline to 24 weeks between BCVA and CST, although change in CST accounted for only 17.5% of the total variation in the change in BCVA.11 Further analysis of the same pooled cohort suggested that CST changes may precede BCVA improvement by up to 6 weeks (3 weeks vs 9 weeks, respectively) following treatment of UME, with earlier CST response significantly associated with better visual prognosis.5
These findings suggest that tracking CST at baseline and across treatment sessions may hold some value in clinical prognostication and patient counseling. However, because correlations between CST and BCVA are at best moderate and fail to account for a large portion of BCVA variability, evaluation of other biomarkers such as those representing severity of retinal tissue damage or structural derangement may provide more information than analysis of CST alone.16
EZ INTEGRITY
The EZ corresponds anatomically to the photoreceptor inner segment–outer segment junction and is thought to represent the mitochondria of photoreceptor inner segments.17 The evaluation of its reflectivity and integrity on OCT imaging serves as an important biomarker of photoreceptor health.17,18
Loss of EZ integrity is associated with decreased visual acuity in a large number of retinal diseases (Figure 2). In UME, the degree of central subfield EZ disruption at baseline was associated with poorer baseline BCVA and poorer response to treatment in the pooled AZALEA/PEACHTREE trial UME cohort, although it may account for less than 30% of the total variation in BCVA, on average.5,11 A smaller study by Grewal et al analyzed 56 eyes from the VISUAL-1 trial of UME and found EZ integrity on OCT to be weakly associated with BCVA when averaged across all visits.19 Finally, degree of EZ disruption has been associated with intensity of corticosteroid therapy required to treat UME.20 These findings suggest that EZ analysis may be helpful in predicting clinical response to treatment; however, as with CST, EZ analysis alone is not sufficient for accurate prognostication in UME.
Figure 2. The intact EZ (arrows) loses its integrity (bracket) within the area of UME. Note the mild serous retinal detachment (between arrow heads) causing significant EZ disruption. Overlying large central cystoid spaces and diffuse ME are also seen.
DRIL
Precise organization of the inner retina is critical to physiologic visual function. Complex interactions between bipolar cells and networks of horizontally and vertically oriented amacrine cells in the inner retinal layers are responsible for processing photoreceptor signals and relaying the visual image to the brain.21 Macular or foveal disruption of these intricate networks may profoundly impact visual acuity.22 DRIL, an OCT biomarker of retinal disease, appears as loss of clearly delineated boundaries between the ganglion cell–inner plexiform layer complex, the inner nuclear layer, and the outer plexiform layer (Figure 3).23

Figure 3. This OCT image demonstrates DRIL in UME. Note the loss of clearly delineated boundaries between the inner retinal layers (between arrows) adjacent to the large central cystoid space.
DRIL has been robustly associated with poorer baseline BCVA and visual prognosis in diabetic ME, even after treatment and resolution of edema.22,24 One study found that the volume of retinal tissue between the inner and outer plexiform layers as determined by OCT imaging predicted 80% of the variance in baseline BCVA compared with 14% predicted by CST; this validates retinal tissue integrity with preserved axonal connections as an indicator of visual function.25 DRIL may also be a sign of inner retinal ischemia or inflammatory neurodegeneration.19
Few studies have assessed DRIL as a biomarker in UME. Grewal et al first reported a significant association between baseline BCVA and both the horizontal and vertical retinal area of foveal DRIL in UME.19 Liu et al similarly found that the transverse and vertical diameter of DRIL on baseline OCT imaging was associated with worse baseline BCVA and poorer final BCVA, while baseline macular thickness was not correlated with improvement in BCVA at 6 months.26 While more research is necessary, these findings suggest that DRIL may ultimately prove to be a robust and useful biomarker of disease severity and prognosis in UME.
MORE WORK AHEAD
Continued research clarifying the precise significance of these biomarkers and others in the diagnosis and management of retinal disease may prove them to be invaluable for guiding the management of UME. Integration of such biomarkers into machine-learning algorithms may ultimately provide the key to developing personalized therapeutic strategies and accurate prognostic guidance in the management of uveitis and other retinal diseases.
1. Rothova A, Suttorp-van Schulten MS, Frits Treffers W, Kijlstra A. Causes and frequency of blindness in patients with intraocular inflammatory disease. Br J Ophthalmol. 1996;80(4):332-336.
2. Accorinti M, Okada AA, Smith JR, Gilardi M. Epidemiology of macular edema in uveitis. Ocul Immunol Inflamm. 2019;27(2):169-180.
3. Yeh S, Khurana RN, Shah M, et al. Efficacy and safety of suprachoroidal CLS-TA for macular edema secondary to noninfectious uveitis: phase 3 randomized trial. Ophthalmology. 2020;127(7):948-955.
4. Henry CR, Shah M, Barakat MR, et al. Suprachoroidal CLS-TA for non-infectious uveitis: an open-label, safety trial (AZALEA). Br J Ophthalmol. 2022;106(6):802-806.
5. Ciulla TA, Kapik B, Barakat MR, et al. Optical coherence tomography anatomic and temporal biomarkers in uveitic macular edema. Am J Ophthalmol. 2022;237:310-324.
6. Markomichelakis NN, Halkiadakis I, Pantelia E, et al. Patterns of macular edema in patients with uveitis: qualitative and quantitative assessment using optical coherence tomography. Ophthalmology. 2004;111(5):946-953.
7. Iannetti L, Spinucci G, Abbouda A, De Geronimo D, Tortorella P, Accorinti M. Spectral-domain optical coherence tomography in uveitic macular edema: morphological features and prognostic factors. Ophthalmologica. 2012;228(1):13-18.
8. Hunter RS, Skondra D, Papaliodis G, Sobrin L. Role of OCT in the diagnosis and management of macular edema from uveitis. Semin Ophthalmol. 2012;27(5-6):236-241.
9. Hee MR, Puliafito CA, Wong C, et al. Quantitative assessment of macular edema with optical coherence tomography. Arch Ophthalmol. 1995;113(8):1019-1029.
10. Diabetic Retinopathy Clinical Research Network. Reproducibility of macular thickness and volume using zeiss optical coherence tomography in patients with diabetic macular edema. Ophthalmology. 2007;114(8):1520-1525.
11. Ciulla TA, Kapik B, Grewal DS, Ip MS. Visual acuity in retinal vein occlusion-, diabetic-, and uveitic macular edema: central subfield thickness and ellipsoid zone analysis. Ophthalmol Retina. 2021;5(7):633-647.
12. Antcliff RJ, Stanford MR, Chauhan DS, et al. Comparison between optical coherence tomography and fundus fluorescein angiography for the detection of cystoid macular edema in patients with uveitis. Ophthalmology. 2000;107(3):593-599.
13. Tran THC, de Smet MD, Bodaghi B, Fardeau C, Cassoux N, Lehoang P. Uveitic macular oedema: correlation between optical coherence tomography patterns with visual acuity and fluorescein angiography. Br J Ophthalmol. 2008;92(7):922-927.
14. Sugar EA, Jabs DA, Altaweel MM, et al. Identifying a clinically meaningful threshold for change in uveitic macular edema evaluated by optical coherence tomography. Am J Ophthalmol. 2011;152(6):1044-1052.e5.
15. Khurana RN, Bansal AS, Chang LK, Palmer JD, Wu C, Wieland MR. Prospective evaluation of a sustained-release dexamethasone intravitreal implant for cystoid macular edema in quiescent uveitis. Retina. 2017;37(9):1692-1699.
16. Cohen LM, Goldstein DA, Fawzi AA. Structure-function relationships in uveitic cystoid macular edema: using en face optical coherence tomography to predict vision. Ocul Immunol Inflamm. 2016;24(3):274-281.
17. Tao LW, Wu Z, Guymer RH, Luu CD. Ellipsoid zone on optical coherence tomography: a review. Clin Exp Ophthalmol. 2016;44(5):422-430.
18. Scoles D, Flatter JA, Cooper RF, et al. Assessing photoreceptor structure associated with ellipsoid zone disruptions visualized with optical coherence tomography. Retina. 2016;36(1):91.
19. Grewal DS, O’Sullivan ML, Kron M, Jaffe GJ. Association of disorganization of retinal inner layers with visual acuity in eyes with uveitic cystoid macular edema. Am J Ophthalmol. 2017;177:116-125.
20. Kessler LJ, Łabuz G, Auffarth GU, Khoramnia R. Biomarkers to predict the success of treatment with the intravitreal 0.19 mg fluocinolone acetonide implant in uveitic macular edema. Pharmaceutics. 2022;14(4):688.
21. Kolb H. Simple anatomy of the retina. In: Kolb H, Fernandez E, Nelson R, eds. Webvision: The Organization of the Retina and Visual System. University of Utah Health Sciences Center; 1995.
22. Sun JK, Radwan SH, Soliman AZ, et al. Neural retinal disorganization as a robust marker of visual acuity in current and resolved diabetic macular edema. Diabetes. 2015;64(7):2560-2570.
23. Sun JK, Lin MM, Lammer J, et al. Disorganization of the retinal inner layers as a predictor of visual acuity in eyes with center-involved diabetic macular edema. JAMA Ophthalmol. 2014;132(11):1309-1316.
24. Radwan SH, Soliman AZ, Tokarev J, Zhang L, van Kuijk FJ, Koozekanani DD. Association of disorganization of retinal inner layers with vision after resolution of center-involved diabetic macular edema. JAMA Ophthalmol. 2015;133(7):820-825.
25. Pelosini L, Hull CC, Boyce JF, McHugh D, Stanford MR, Marshall J. Optical coherence tomography may be used to predict visual acuity in patients with macular edema. Invest Ophthalmol Vis Sci. 2011;52(5):2741-2748.
26. Liu Z, Tao QQ, Li XR, Zhang XM. Disorganization of the retinal inner layers as a predictor of visual acuity in eyes with macular edema secondary to uveitis. Int J Ophthalmol. 2021;14(5):725-731.





















